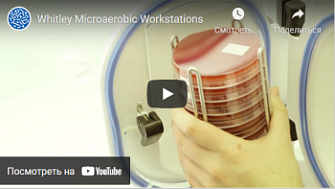

Вход в личный кабинет
Оформление заказа без регистрации
Для продолжения регистрации введите ИНН
Восстановление пароля
Ссылка для восстановления пароля будет отправлена на Ваш адрес электронной почты
Регистрация пользователя
Заполните, пожалуйста, форму регистрации
Все поля со звездочкой (*) обязательны для заполнения
Все поля со звездочкой (*) обязательны для заполнения
Техподдержка пользователей
Для более быстрого оформления запроса выберите тему обращения
Отмена регистрации
Вы уверены, что хотите отменить создание учетной записи и удалить все данные?
Данное действие необратимо.
Данное действие необратимо.
Да, удалить
Нет, оставить
Зарегистрируйтесь на dia-m.ru,
чтобы сделать работу на сайте еще удобнее!
чтобы сделать работу на сайте еще удобнее!
С помощью личного кабинета Вы сможете:
- моментально получать счета на оформленные заказы;
- отслеживать статусы выполнения заказа по оплате, отгрузке, наличию товаров на складе;
- вести историю заказов, повторять заказы полностью или частично;
- выбирать персонального менеджера;
- формировать списки избранного среди товаров, справочных материалов и видео;
- делать заказ со страницы избранных товаров;
- экономить время при заполнении форм заказа по каталогам и регистрации на мероприятия.